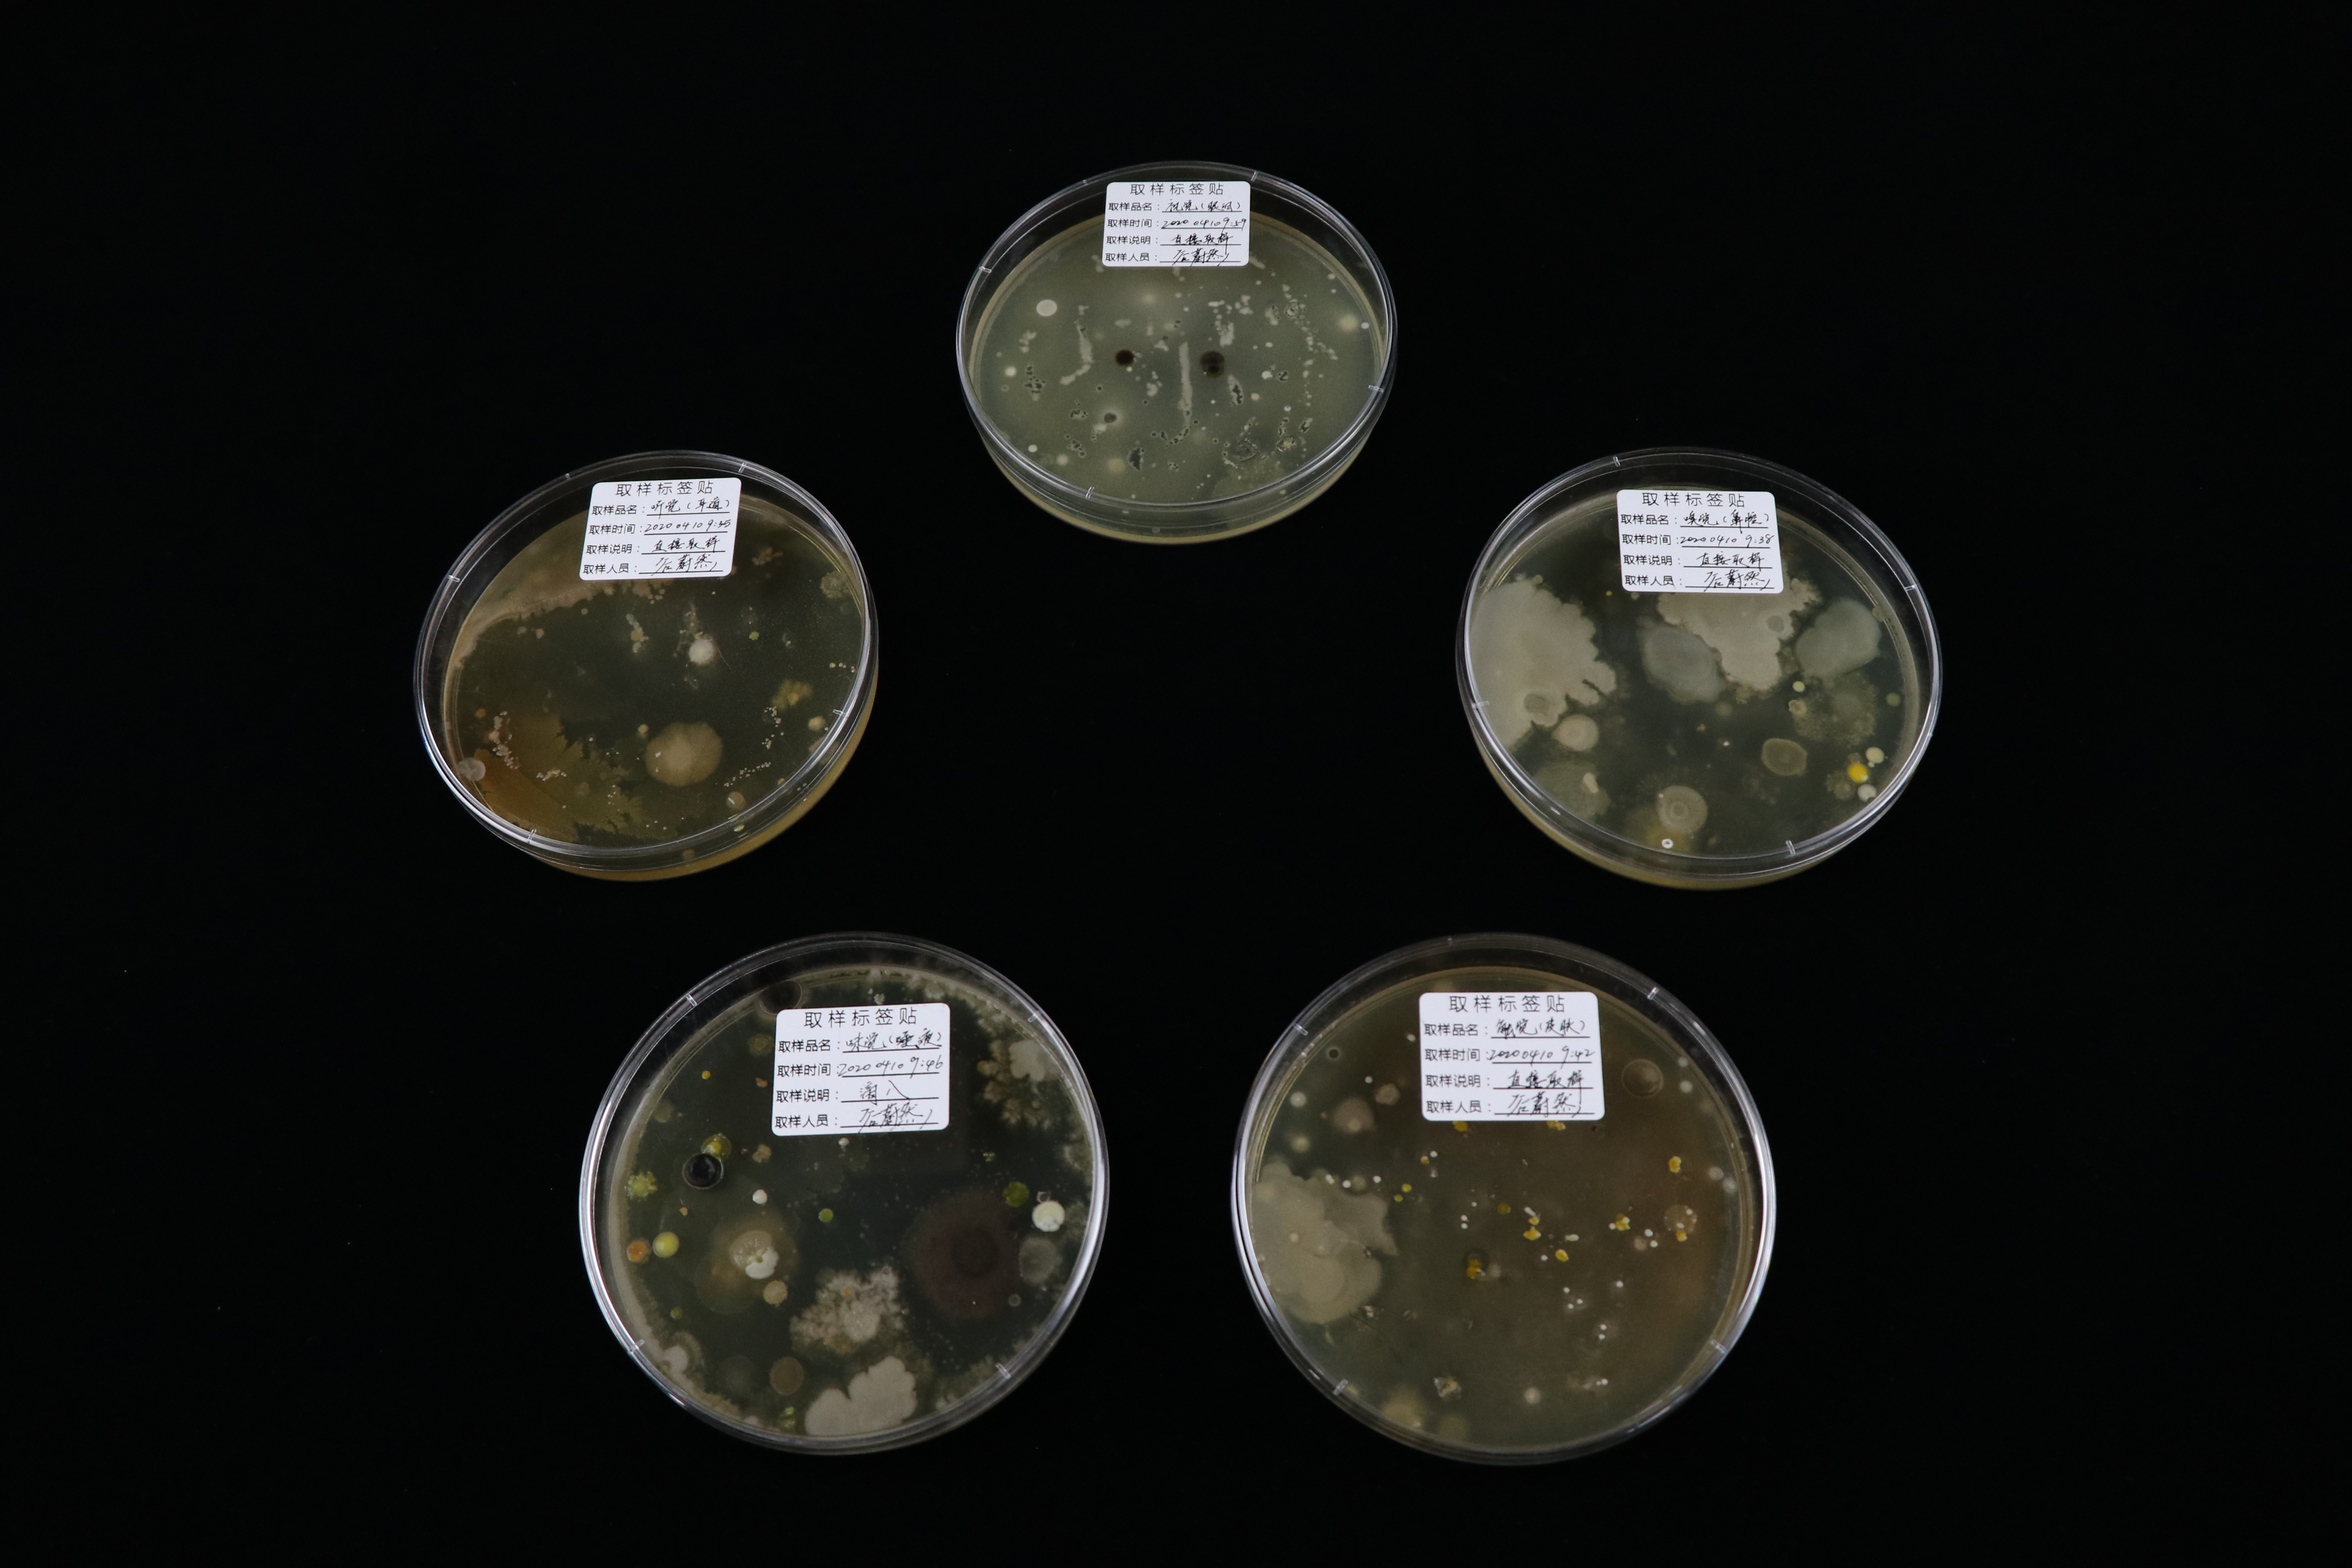
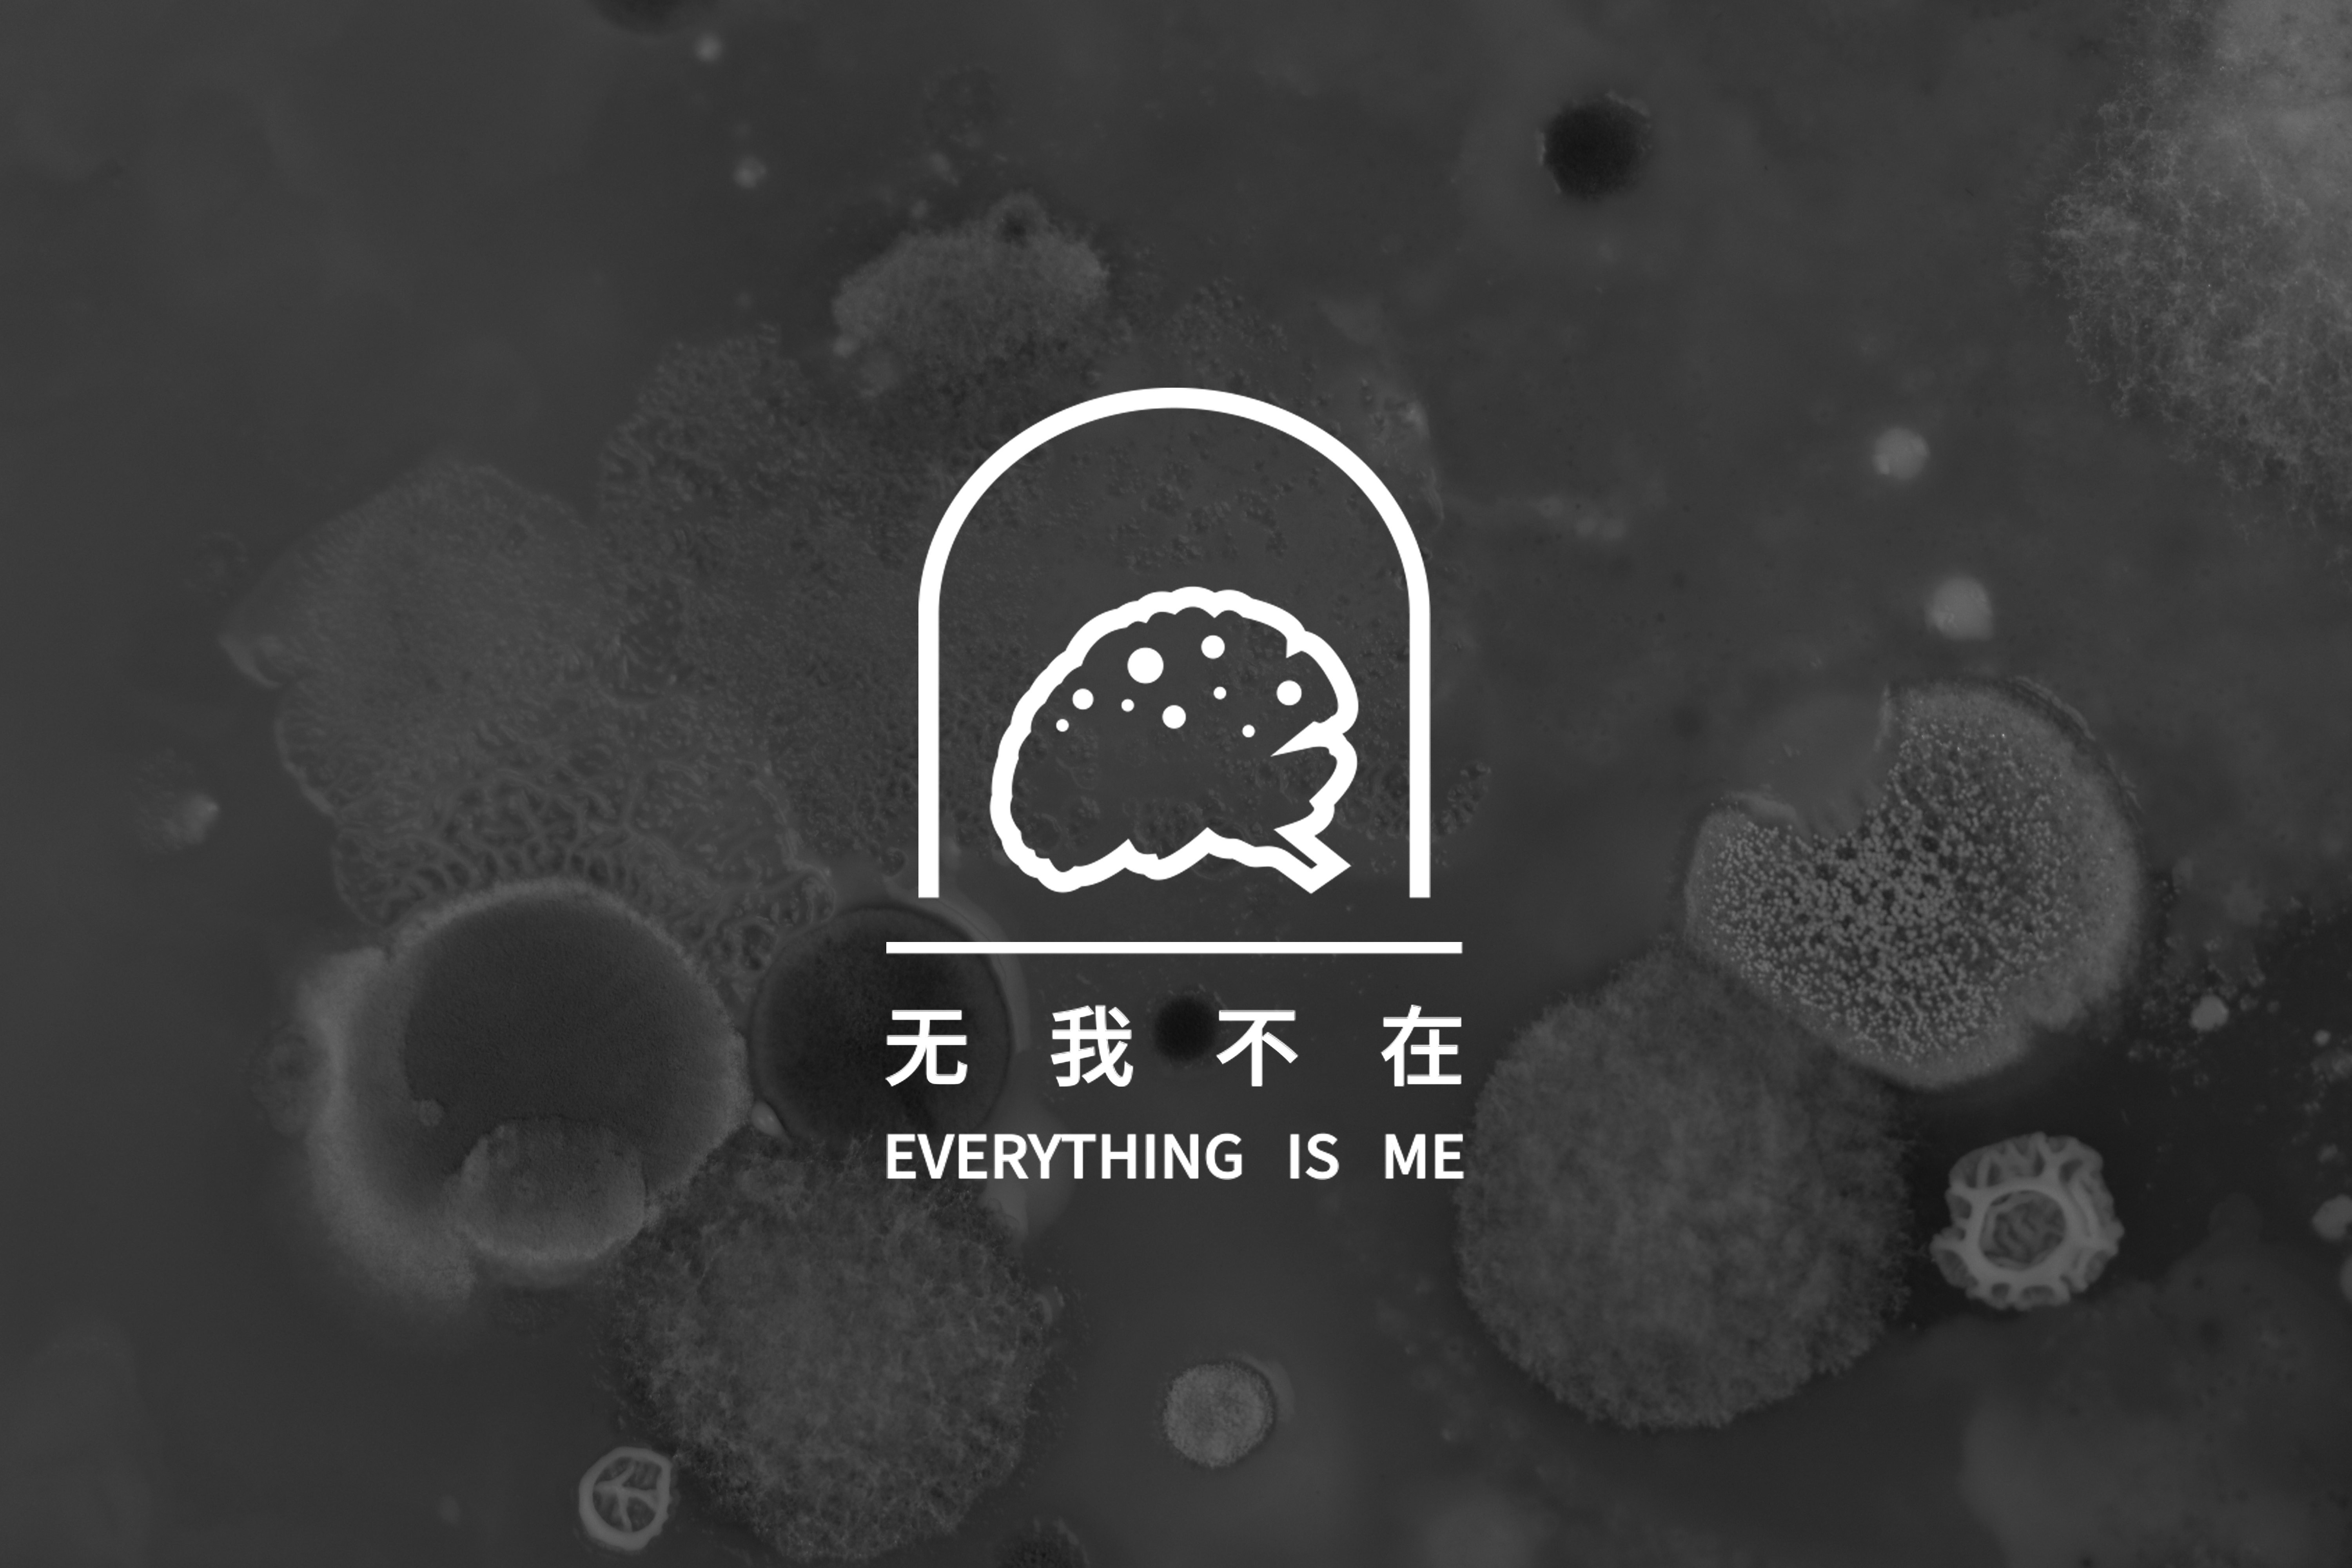

中英数字媒体艺术学院毕业生作品(03)
1
300
查看原图
中英数字媒体艺术学院_王荣贺_影子的影子 _ 辽南皮影的数字化重构 系列海报其四_1592480747_145259
【类型】图片
【相册名称】 中英数字媒体艺术学院毕业生作品(03)
【摘要】中英数字媒体艺术学院毕业生作品(03)
热点排行
推荐内容






































































































_1592493084_329833.jpg)
_1592493048_133499.jpg)
_1592492936_710935.jpg)
_1592384055_721297.jpg)





























































—— AR全景互动空间动态视频展示_1592481534_436014.jpg)
—— 减压效应器_1592453311_844880.jpg)
—— 压感效应器_1592453237_857315.jpg)
—— 共压效应器_1592453030_666599.jpg)
—— 消压效应器_1592453513_385967.jpg)
—— 压强效应器_1592452871_241539.jpg)

【类型】图片
【相册名称】 中英数字媒体艺术学院毕业生作品(03)
【摘要】中英数字媒体艺术学院毕业生作品(03)